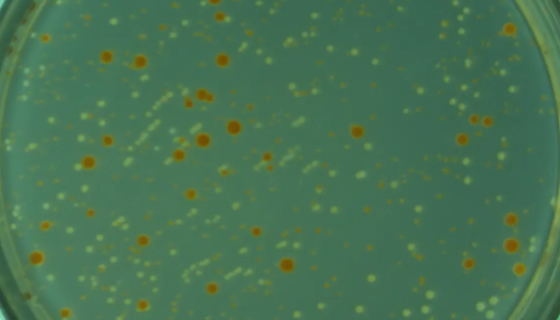
洋葱假单胞菌的特征特性及冻干管打管说明！

ATCC 12757小白链霉菌的特点与优势及培养方法!
小白链霉菌孢子丝螺旋形,相当紧密,可达6—7圈。孢子椭圆形,...

非洲哈茨木霉的打管说明及培养条件与注意事项!
非洲哈茨木霉,菌落呈广铺的棉絮状,起初为白色致密的平坦菌丝,...

RWPE-1人正常前列腺上皮细胞的培养步骤与应用!
RWPE-1人正常前列腺上皮细胞来自一位54岁白人男性的正常...

意大利青霉——工业用防腐剂的效果检测
意大利青霉是无性型真菌门、半知菌纲、壳霉目、杯霉科中的一种真...
洋葱假单胞菌的特征特性及冻干管打管说明!
洋葱假单胞菌,较长有染色不匀,最先在腐烂的洋葱上发现,过去被...

用于酿造白酒和产淀粉酶的:橙色嗜热子囊菌
橙色嗜热子囊菌是Thermoascus属的微生物,原产地为中...

皱纹假单胞菌的使用范围与培养方法及实验内容!
皱纹假单胞菌是Pseudomonas属的微生物,原产地为英国...

毕赤酵母的开发利用与生产过程及纯化方法!
毕赤酵母,甲醇营养型酵母中的一类能够利用甲醇作为碳源和能源的...

ATCC 18943 解脂复膜孢酵母(亚罗解脂酵母)
解脂复膜孢酵母是Saccharomycopsis属的微生物,...